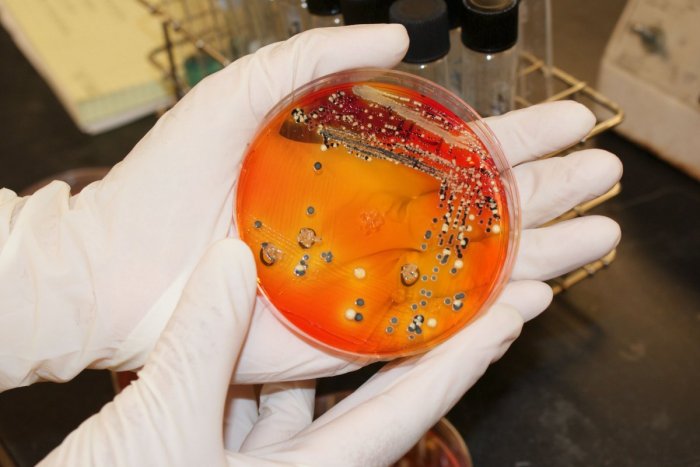
Ilustračný obrázok k článku Vyhnite sa v lete salmonelóze: Odborník RADÍ, na čo všetko si dať POZOR

Vyhnite sa v lete salmonelóze: Odborník RADÍ, na čo všetko si dať POZOR
Najčastejšie sa vznik akútneho bakteriálneho hnačkového ochorenia vyskytuje u detí v predškolskom veku a u starších ľudí, avšak vnímané je u všetkých vekových kategórií.
Salmonelóza sa najčastejšie prenáša nedostatočne tepelne upraveným kontaminovaným mäsom, ako aj tepelne neupraveným mliekom a slepačími vajcami či výrobkami z nich. Vedúca Národného referenčného centra pre salmonelózy Úradu verejného zdravotníctva (ÚVZ) SR Dagmar Gavačová preto radí okrem správnej prípravy dodržiavať aj osobnú hygienu, dostatočné čistenie pracovných plôch a nástrojov, ale aj správnu manipuláciu a skladovanie surovín a jedál.
Čo nerobiť?
„Nenechávajte jedlá, potraviny a nápoje na priamom slnku, či už pri bazéne, na terase chaty alebo v aute,“ doplnila s tým, že nedodržiavanie týchto zásad môže byť príčinou nákazy.
Baktérie salmonely sa v potravinách dokážu množiť a prežívajú aj pri chladničkovej teplote a v mrazených potravinách. Ničí ich teplota 70 stupňov Celzia, preto Gavačová odporúča vyhnúť sa v horúcich mesiacoch vajíčkam namäkko a volské oko opražiť z oboch strán.
Bezpríznakovými nosičmi salmonel sú často aj zvieratá v kontaktných zoologických záhradách, zooparkoch, na putovných výstavách plazov a na burzách s predajom zvierat.
Je preto potrebné, aby sa s nimi deti hrali pod dozorom dospelej osoby a po kontakte so zvieraťom si dokonale umyli ruky. „Malo by sa zabrániť kontaktu zvierat (plazov) a detí do päť rokov a odporúčame nekonzumovať potraviny počas prehliadky zvierat,“ uviedla Gavačová.
U koho je najčastejšie?
Najčastejšie sa vznik akútneho bakteriálneho hnačkového ochorenia vyskytuje u detí v predškolskom veku a u starších ľudí, avšak vnímané je u všetkých vekových kategórií. Príznaky sa môžu prejaviť o šesť až 72 hodín po skonzumovaní kontaminovaného jedla.
„Nakazený človek máva vysokú teplotu, pociťuje nevoľnosť, zvracia, má kŕčovité bolesti brucha a časté vodnaté stolice. Nebezpečná pri salmonelóze je strata tekutín,“ upozornila Gavačová s tým, že ťažká dehydratácia organizmu si v mnohých prípadoch vyžiada hospitalizáciu a infúznu liečbu.
ilustračné foto